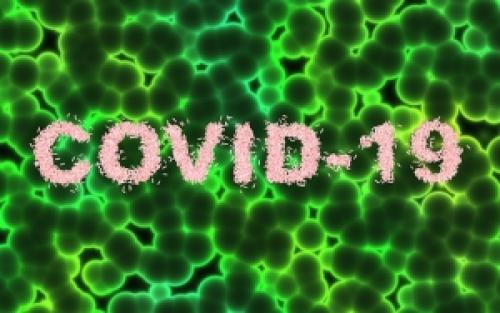
Какие факторы влияют на тяжесть COVID-19 и ORVI. Исследование на факторы риска тяжелого течения COVID-19 и других ОРВИ

COVID-19 vs ORVI: Как отличить вирусную инфекцию от коронавируса
- COVID-19 vs ORVI: Как отличить вирусную инфекцию от коронавируса
- Связанные вопросы и ответы
- Что такое COVID-19 и ORVI
- Какие симптомы наблюдаются при COVID-19 и ORVI
- Как COVID-19 и ORVI передаются от человека к человеку
- Как происходит диагностика COVID-19 и ORVI
- Как лечится COVID-19 и ORVI
- Какие меры предосторожности следует принимать для предотвращения COVID-19 и ORVI
- Какие группы населения более уязвимы для COVID-19 и ORVI
- Как COVID-19 и ORVI влияют на иммунитет
COVID-19 vs ORVI: Как отличить вирусную инфекцию от коронавируса
Входные ворота — эпителий верхних дыхательных путей, эпителиальные клетки желудка и кишечника . Коронавирус проникает в клетки, имеющие рецепторы ангиотензинпревращающего фермента II типа (ACE2) , там он накапливается и размножается. Из носоглотки вирус распространяется по кровеносным сосудам, поражая клетки нижних дыхательных путей, желудка, кишечника, проникая глубже в ткань. В большинстве случаев данный процесс самостоятельно ограничивается, что приводит к полному выздоровлению по мере формирования запаса защитных антител в организме.
Респираторный тракт
При инфекции COVID-19 вирусы могут продолжать выделяться даже спустя некоторое время после их исчезновения из дыхательных путей. Это указывает на вероятность более позднего фекально-орального механизма передачи заболевания.
При одновременном отсутствии иммунитета к инфекции и наличии иммунодефицита на фоне сопутствующих заболеваний вирус может прорвать иммунную защиту и массивно распространиться по тканям организма. Так, например, происходит при заражении новым штаммом SARS-CoV-2. Распространение инфекции ведёт к каскаду патологических реакций, в ходе которых прогрессирует поражение альвеол, возникает тяжёлая дыхательная недостаточность и наступает смерть. Схематично это можно представить следующим образом:
- в ответ на воспалительный процесс образуются провоспалительные факторы, которые активируют альвеолярные нейтрофилы и макрофаги — клетки, пожирающие чужеродные и ненужные субстанции;
- нейтрофилы прикрепляются к внутренней поверхности лёгочных капилляров и вызывают цитокиновый шторм: они высвобождают цитотоксические факторы (в том числе агрессивные соединения кислорода), которые повреждают стенки мелких альвеолярных сосудов .
- из-за повреждения сосудов воспалительная жидкость (экссудат) проникает в само воздушное лёгочное пространство, что ведёт к гипоксии — кислородному голоданию;
- также из-за повреждения клеток нарушается выработка сурфактанта — вещества, препятствующего спаданию альвеол.
- на фоне спадения альвеол усиливается гипоксия, снижается жизненная ёмкость лёгких. В результате в лёгочной артерии образуются тромбы, развивается лёгочная гипертензия — повышение давления в малом круге кровообращения. Тяжёлая лёгочная гипертензия может привести к сердечной недостаточности и летальному исходу .
Экссудат
Вирус одинаково влияет на организм человека независимо от возраста. Опасность для пожилых и ослабленных людей заключается лишь в разбалансировке работы организма и ухудшении уже имеющихся хронических заболеваний. Подобное происходит и при других возбудителях респираторных инфекций, например при гриппе . Однако опасность нового коронавируса заключается в более частом развитии осложнений из-за полной неспособности иммунитета противостоять неизвестному для него патогену.
Связанные вопросы и ответы:
Вопрос 1: Какие симптомы COVID-19 и орви имеют сходство
Ответ: COVID-19 и орви могут иметь сходные симптомы, такие как кашель, насморк, температура, головная боль, усталость и боль в мышцах. Однако, COVID-19 может также вызывать потерю обоняния и вкуса, а также более тяжелые симптомы, такие как одышка и проблемы с дыханием.
Вопрос 2: Как отличить COVID-19 от орви по симптомам
Ответ: COVID-19 и орви могут иметь сходные симптомы, но есть некоторые отличия. COVID-19 может вызывать потерю обоняния и вкуса, а также более тяжелые симптомы, такие как одышка и проблемы с дыханием. Орви обычно вызывает более лёгкие симптомы, такие как кашель, насморк, температура и головная боль.
Вопрос 3: Как отличить COVID-19 от орви по тесту на COVID-19
Ответ: Тест на COVID-19 может помочь отличить COVID-19 от орви. Тест на COVID-19 обычно делается с помощью аспирации слизи из носа или глотки. Если результат теста положительный, то это указывает на наличие COVID-19. Если результат теста отрицательный, то это не исключает наличие COVID-19, но может указывать на орви или другие вирусные инфекции.
Вопрос 4: Как отличить COVID-19 от орви по анализу крови
Ответ: Анализа крови может помочь отличить COVID-19 от орви. При COVID-19 может быть повышенный уровень белка С-реактивного (СРБ) и лейкоцитов, а также сниженная концентрация кислорода в крови. Орви обычно не вызывает значительных изменений в анализе крови.
Вопрос 5: Как отличить COVID-19 от орви по компьютерной томографии лёгких
Ответ: Компьютерная томография лёгких может помочь отличить COVID-19 от орви. При COVID-19 на компьютерной томографии могут быть видны инфильтраты в лёгких, которые могут быть как односторонними, так и двусторонними. Орви обычно не вызывает изменений на компьютерной томографии лёгких.
Вопрос 6: Как отличить COVID-19 от орви по медицинскому анализу
Ответ: Медицинский анализ может помочь отличить COVID-19 от орви. При COVID-19 могут быть выявлены признаки воспаления, такие как повышенный уровень белка С-реактивного (СРБ) и лейкоцитов. Орви обычно не вызывает значительных изменений в медицинском анализе.
Что такое COVID-19 и ORVI
КОВИД-19, грипп — это разновидности ОРВИ (острых респираторных вирусных инфекций), возбудителями которых являются респираторные вирусы. Симптоматика всех заболеваний схожа, но некоторые отличия есть. Грипп развивается стремительно, состояние здоровья ухудшается буквально за 2-4 часа. Для ОРВИ характерен замедленный режим развития. 2-3 дня человека преследует легкое недомогание, потом появляются первые признаки — насморк, субфебрильная температура, боль в горле. Коронавирус чаще дебютирует незначительным повышением температуры, першением в горле, слабостью.
При ОРВИ слабо выражены симптомы интоксикации, тогда как при гриппе и коронавирусе отравление вирусными токсинами проявляется довольно ярко. Пациенты жалуются на тошноту, головную боль, ломоту в мышцах и суставах.
Для гриппа и ОРВИ характерны частое чихание, ринорея (течение из носа). При КОВИД-19 слизистые практически не реагируют на вторжение вируса, зато пропадает обоняние. При ОРВИ и гриппе аносмии попросту не бывает.
Отличить заболевания можно по динамике гипертермии. Гриппозная инфекция проявляется резким повышением температуры до 39℃. При ОРВИ гипертермия не пересекает границу 38 ℃. Коронавирус может протекать без температуры или с невысокими температурными значениями на начальном этапе заболевания.
В список симптомов гриппа входят покраснение глаз, воспаление конъюнктивы, слезотечение, болезненная чувствительность к свету. Для коронавируса и ОРВИ поражение органов зрения не характерно.
COVID-19 and ORVI (Ostрые Респираторные Вирусные Инфекции) are both caused by respiratory viruses, but they have distinct differences in their symptoms and progression.
Symptoms of COVID-19:
- Nasal congestion and runny nose
- Sore throat
- Fever, which may be mild or severe
- Loss of smell and taste
- Fatigue and weakness
Symptoms of ORVI:
- Mild to moderate fever
- Cough
- Sore throat
- Runny nose
- Mild fatigue
One of the main differences between COVID-19 and ORVI is the severity of the symptoms. COVID-19 can cause severe respiratory distress, while ORVI is generally milder.
How to tell the difference:
- COVID-19: Symptoms tend to develop rapidly, with fever, cough, and shortness of breath appearing within 2-4 days of infection.
- ORVI: Symptoms tend to develop more slowly, with fever, cough, and runny nose appearing 2-3 days after infection.
- COVID-19: Loss of smell and taste is a common symptom, while ORVI does not typically cause these symptoms.
- COVID-19: Fever is often high and can be severe, while ORVI fever is generally milder.
It's important to note that both COVID-19 and ORVI can cause similar symptoms, such as fever, cough, and runny nose. However, the severity and progression of the symptoms can help distinguish between the two.
Какие симптомы наблюдаются при COVID-19 и ORVI
Характерный признак коронавируса — нарушения работы обонятельных и вкусовых рецепторов. Больной полностью или частично перестаёт чувствовать запахи, искажённо ощущает или совсем не ощущает вкус блюд.
Это наиболее распространённый симптом COVID-19, но сам по себе он ещё ни о чём не говорит. Иногда коронавирус протекает без потери обоняния и вкуса, а иногда такие изменения наблюдаются при обычной простуде.
Другие распространённые симптомы коронавируса:
затяжные приступы кашля, преимущественно сухого;
болезненные ощущения, чувство тяжести в груди;
заложенность носа без выраженного насморка;
затруднения дыхания: боль при вдохе, чувство сдавленности, одышка;
стойкое повышение температуры от 37 °C и выше;
кожный зуд, сыпь, покраснение, отёчность тканей;
сильная головная боль, мигрень;
болезненные ощущения в мышцах, суставах, костях;
слабость, разбитость.
Также при коронавирусе могут наблюдаться симптомы, вызванные интоксикацией: тошнота, рвота, диарея, побледнение кожных покровов, отсутствие аппетита.
Пневмония при коронавирусе
Двусторонняя пневмония — клиническое проявление коронавируса, возникающее примерно у 20 % больных. В группу риска входят пациенты старше 60 лет, а также лица с хроническими заболеваниями, приводящими к нарушению иммунитета: сахарным диабетом, артериальной гипертензией, обструктивной болезнью лёгких.
Симптомы пневмонии при коронавирусе:
температура выше 38 или ниже 36 °C, сохраняющаяся не менее пяти дней;
одышка, наблюдающаяся даже в состоянии покоя;
боль в груди, ощущение нехватки воздуха при дыхании;
длительные, болезненные приступы сухого кашля;
сонливость, слабость, повышенная потливость;
нестабильное артериальное давление, нарушенный сердечный ритм;
сильная мигрень;
тошнота, рвота;
спутанность сознания.
Как COVID-19 и ORVI передаются от человека к человеку
Основной механизм передачи гриппа и ОРВИ – аэрозольный , или воздушно-капельный 1. Распространение инфекции происходит следующим образом: когда больной человек чихает или кашляет, из его рта вылетают мельчайшие капельки слюны и слизи. В них содержатся вирусные частицы, которые разлетаются на несколько метров вокруг больного. Капли находятся воздухе, который вдыхает другой человек, находящийся рядом. Вирусные частицы попадают на слизистую оболочку носа и глотки, проникают внутрь клеток и начинают размножаться. Если защитных сил организма оказывается недостаточно, чтобы побороть инфекцию – человек заболевает, и уже сам продолжает передавать болезнь воздушно-капельным путем.
Можно заразиться гриппом и ОРВИ даже при непродолжительном, но близком контакте с больным, который много чихает и кашляет . Особенно опасны в плане передачи острых респираторных инфекций те, кто во время болезни продолжают ходить на учебу или на работу. В помещении люди находятся близко друг к другу и чаще контактируют. Кроме того, играет роль и качество воздуха – при редком проветривании быстро растет количество вирусных частиц в воздухе, а из-за отсутствия увлажнителя слизистые оболочки носа пересыхают и перестают полноценно противостоять инфекции.
Существует другой путь распространения ОРЗ – контактный . Например, в момент чихания или кашля человек прикрывает рот рукой, пытаясь остановить распространение капелек слюны. Но в результате огромное количество вирусных частиц остается на руках больного, которыми он затем касается различных поверхностей и предметов – ручек дверей, посуды, выключателей, пульта от телевизора. Помимо этого, вирусные частицы, попавшие в воздух, оседают на предметы быта и одежду, которые потом трогает другой человек. Разные типы вирусов могут оставаться активными в окружающей среде от нескольких часов до нескольких дней. Поэтому так важно часто мыть руки и не касаться ими лица в разгар эпидемического сезона .
Редкий, но возможный путь передачи – алиментарный , через продукты питания. Так могут передаваться аденовирусы. Заражение происходит при употреблении инфицированной пищи или воды.

Как происходит диагностика COVID-19 и ORVI
КЛИНИЧЕСКИЕ ОСОБЕННОСТИ
Инкубационный период составляет от 2 до 14 суток, в среднем 5-7 суток.
Для COVID-19 характерно наличие клинических симптомов ОРВИ:
• Повышение t тела (> 90%);
• Кашель (сухой или с небольшим количеством мокроты) в 80% случаев;
• Одышка (30%);
• Утомляемость (40%);
• Ощущение заложенности в грудной клетке (> 20%).
Также могут отмечаться боль в горле, насморк, снижение обоняния и вкуса, признаки конъюнктивита.
Наиболее тяжелая одышка развивается к 6-8-му дню от момента заболевания. Также установлено, что среди первых симптомов могут быть миалгия (11%), спутанность сознания (9%), головные боли (8%), кровохарканье (2-3%), диарея (3%), тошнота, рвота, сердцебиение. Данные симптомы в начале болезни могут наблюдаться и при отсутствии повышения температуры тела.
Клинические варианты и проявления COVID-19:
• ОРВИ (поражение только верхних отделов дыхательных путей);
• Пневмония без дыхательной недостаточности;
• ОРДС (пневмония с ОДН);
• Сепсис, септический (инфекционно-токсический) шок;
• ДВС-синдром, тромбозы и тромбоэмболии.
Гипоксемия (SpO2 Классификация COVID-19 по степени тяжести
Легкое течение
• Т тела
• Отсутствие критериев среднетяжелого и тяжелого течения
Среднетяжелое течение
• Т тела > 38 °C
• ЧДД > 22/мин
• Одышка при физических нагрузках
• Изменения при КТ (рентгенографии), типичные для вирусного поражения
• SpO2
• СРБ сыворотки крови >10 мг/л
Тяжелое течение
• ЧДД > 30/мин
• SpO2 ≤ 93%
• PaO2 /FiO2 ≤ 300 мм рт.ст.
Как лечится COVID-19 и ORVI
Основные меры неспецифической профилактики от COVID-19, которые необходимо соблюдать для сохранения здоровья:
1. Не прикасаться руками к лицу. В среднем человек за час 25 раз трогает свое лицо руками. При этом этими же руками люди касаются разных поверхностей, на которых может находиться вирус. В половине случаев заражение происходит посредством проникновения вируса через слизистые – глаза, рот, нос.
2. Мыть руки. Такая вроде бы простая и элементарная процедура на настоящий момент считается самой эффективной среди мер неспецифической профилактики COVID-19. Руки надо мыть как можно чаще, причем делать это нужно в течение 40-60 секунд. Если вы моете руки в общественном месте, кран после мытья рук следует закрывать одноразовым полотенцем, которым вы вытерли руки. Рекомендуется использовать жидкое мыло, так как на твердом мыле могут остаться микроорганизмы.
3. Использовать антисептики. Длительность обработки рук составляет 20-30 секунд. Но при покупке данных средств важно обращать внимание на состав. Рекомендуемая концентрация – 80% этанола, 1,45% глицерина, 0,125% перекиси водорода.
4. Если во время чихания и кашля прикрывать рот и нос, экспансию COVID-19 можно предотвратить. Кашлять и чихать нужно в салфетку, а если ее под рукой нет – в сгиб локтя. После использования салфетки, ее нужно сразу же выбросить в мусорный контейнер. Многие люди прикрывают рот и нос во время кашля и чихания ладонями – это неправильно и достаточно опасно. Вирус попадает на руки, которыми человек впоследствии прикасается к различным предметам.
5. Носить маску. Маска должна плотно прилегать к лицу, зазоров не должно оставаться. Менять маску нужно каждые 2-3 часа, повторно использовать ее нельзя.
6. Избегать близких контактов, по возможности оставаться на самоизоляции, от других людей держаться на расстоянии не менее 1 метра. Избегать рукопожатий, объятий. Лучшим вариантом является домашняя самоизоляция.
7. Проветривание помещения. Приток свежего воздуха снижает вирусную нагрузку.
Меры неспецифической профилактики для пожилых людей:
1. Оставаться дома, избегать поездок в общественном транспорте, не находиться в местах массового скопления людей.
2. Заказывать продукты с доставкой на дом или через родственников.
3. Укреплять иммунитет при помощи витаминов и других средств.
4. Делать чаще влажную уборку, проветривать помещение.
Риск заражения после 65 лет увеличивается, особенно тяжело вирусная инфекция протекает у лиц, имеющих хронические заболевания. Пожилым людям рекомендуется оставаться дома и ограничить близкие контакты с другими людьми, при общении обязательно соблюдать дистанцию.
Конечно пожилым людям следует доставлять продукты питания и необходимые лекарства, но, приходя к ним, следует обязательно надевать маску. Это связано с тем, что многие люди переносят инфекцию в бессимптомной или легкой форме, но выделяют вирус в окружающую среду.
Если пожилые родственники проживают вместе с вами, то при возможности их нужно поселить в отдельную, хорошо проветриваемую комнату, при общении с ними надевать маску и проводить уборку с использованием дезинфицирующих средств.
Профилактика коронавируса COVID-19 в организациях
Работодателям рекомендуется обеспечить:
1. Обработку рук работников при входе в организацию или предприятие.
2. Контроль температуры работников при входе в организацию и в течение дня. Температура должна измеряться бесконтактным способом. При обнаружении сотрудника с повышенной температурой тела, его нужно срочно отстранить от работы и вызвать медицинскую помощь.
3. Контроль соблюдения самоизоляции сотрудников на дому при установленном контакте с больным COVID-19.
4. Информирование работников о соблюдении правил личной и общественной гигиены.
5. Качественную уборку помещений с использованием дезинфицирующих средств, разведенных по вирусной этиологии. Кратность обработки поверхностей – каждые 2 часа.
6. Регулярное (каждые 2 часа) проветривание помещения.
7. Использование в помещениях бактерицидных ламп с целью обеззараживания воздуха.
Необходимо ограничить:
- проведение корпоративных мероприятий;
- направление сотрудников в командировки.
Условия питания работников:
1. Использовать посуду одноразового применения. Если используется посуда многоразового применения, ее нужно дезинфицировать в специальных моечных машинах при температуре не ниже 65 градусов в течение 90 минут.
Какие меры предосторожности следует принимать для предотвращения COVID-19 и ORVI
При анализе смертности в РФ по официальным данным, опубликованным на сайте Росстата , видно, что средняя смертность за последние 5 лет в период с 2015 года по 2019 год включительно составляла около 5 069 человек ежедневно . Некоторое снижение отмечено в 2019 году, когда смертность составила 4 926 человек в сутки.
На момент подготовки данного заключения в РФ было зафиксировано 53 096 смертельных случаев от новой коронавирусной инфекции . Количество смертей от новой коронавирусной инфекции за 10 месяцев составляет всего 10–11 дневную ежегодную смертность в РФ по многолетним наблюдениям. К тому же чрезвычайно интересным будет количество случаев внебольничной пневмонии в общем количестве смертей. Пока эта информация не размещена на официальных сайтах и требует дальнейшего изучения, однако она представляется крайне интересной в аспекте изучения действительной смертности от новой коронавирусной инфекции.
Этот факт лучше рассматривать с тем, как фиксируются смертельные случаи от новой коронавирусной инфекции. Сведения о числе зарегистрированных умерших с установленным диагнозом коронавирусной инфекции распределяются по группам:
- COVID-19, вирус идентифицирован;
- возможно COVID-19, вирус не идентифицирован;
- COVID-19 не является основной причиной смерти, но оказал существенное влияние на развитие смертельных осложнений заболевания;
Все эти смерти сводятся в одну общую цифру «смертности от новой коронавирусной инфекции» , хотя в действительности только от COVID-19 умирает не более 30%. Таким образом, показанные цифры (свыше 53 тыс. смертей за 10 месяцев) на момент составления заключения, при детальном рассмотрении в реальности будут в 3 раза меньше ! Большинство погибших имели сопутствующие заболевания, поэтому нельзя уверенно сказать, что пациент умер от COVID-19, а не с COVID-19, даже если считать диагноз подтверждённым.
Общее число смертности на момент подготовки экспертного заключения не было опубликовано на сайте Росстата, данные были обновлены 10.12.2020 и показывали смертность за 10 месяцев 2020 года, которая составила 1661,4 тыс. человек, что превышает показатели смертности за аналогичный период 2019 года (1510,2 тыс. чел.) более чем на 151 тыс. смертей. Даже если вычесть необработанные данные по смертности от новой коронавирусной инфекции (53 тыс. чел.), то увеличение смертности за 10 месяцев 2020 года по сравнению с аналогичным периодом составило около 100 тыс. смертей не связанных никоим образом с новой коронавирусной инфекцией.
Какие группы населения более уязвимы для COVID-19 и ORVI
— Существуют ли препараты, которые помогают избежать фатального исхода и тяжёлых осложнений?
— При COVID-19 одним из самых грозных осложнений является цитокиновый шторм (неконтролируемое воспаление, которое приводит к повреждению собственных тканей организма — Ред.). Ведь люди погибают не от самой инфекции. Их убивает собственный иммунитет, который в ответ на активность медиаторов воспаления начинает пожирать свои же клетки.
В арсенале врачей имеется несколько противовоспалительных препаратов для борьбы с цитокиновым штормом. Например, ингибиторы интерлейкина-6. Но у большинства пациентов, которые их принимают, развивается уже не вирусная, а бактериальная пневмония. То же самое можно сказать и о стероидных препаратах, которые хоть и усмиряют воспаление, одновременно подавляют работу иммунной системы, тем самым провоцируя размножение других бактерий и патогенов.
— В таком случае может ли стать панацеей использование иммуномодуляторов?
— Панацеей — нет, потому что такие препараты не могут приводить к уничтожению вируса. Но они вполне могут быть дополнением к базисной терапии, так как помогают устранить дефект в работе иммунной системы и смоделировать адекватный иммунный ответ. Ведь роль иммунитета при коронавирусной инфекции — основная. Если он у человека крепкий, болезнь протечёт в лёгкой форме. Однако любой иммуномодулятор должен применяться только в сочетании с другими препаратами.
— Какие группы препаратов можно применять для профилактики?
— На сегодняшний день нет ни одного препарата, который мог бы на 100% защитить от заражения. Однако у нас в стране есть масса лекарств для неспецифической профилактики респираторных инфекций. Например, препараты интерферонов (индукторы интерферона). Также существуют иммунотропные препараты, влияющие не только на интерфероновый статус, но и на другие звенья иммунитета. Они способствуют нормализации клеточного иммунитета, который сильно повреждается при инфекции, и помогают иммуннной системе переходить из фазы возмущения в фазу спокойствия.
Иммунотропные препараты можно применять на любом этапе болезни: и в начале, и в середине, и в конце, и на этапе реабилитации. Ведь после ковид-инфекции организм сильно ослаблен в течение как минимум 3 месяцев. Больные испытывают головокружение, слабость, снижение памяти, психогенные нарушения.
Сейчас один из популярных российских иммуномодуляторов — полиоксидоний — участвует в международном клиническом исследовании по протоколу ВОЗ, которое изучает его эффективность при лечении COVID-19. Это демонстрирует высокий уровень наших учёных и врачей. Я очень рад этому и горд за отечественную науку.
Этот препарат доказывает, что он может моделировать иммунный ответ и работать как в начале заболевания, так и в середине и в конце его. Ведь он стимулирует клеточные механизмы, которые сильно нарушаются при лечении.
Препарат имеет два направления: как профилактическое и как вспомогательное средство в лечении на период реабилитационного восстановления организма.
Как COVID-19 и ORVI влияют на иммунитет
Сегодня все мы находимся в зоне риска по COVID-19. Как оценить свои шансы на тяжелое течение этой болезни, гриппа и других ОРВИ, будучи здоровым или имея сопутствующие хронические заболевания?
В филиале на Тверитина, 34/10 мы предлагаем комплексное исследование для оценки состояния различных органов и систем организма, чтобы прогнозировать тяжелое течение и высокий риск осложнений, снизить вероятность их развития на фоне коронавирусной инфекции.
В филиале на Тверитина, 34/10 мы предлагаем комплексное исследование для оценки состояния различных органов и систем организма, чтобы прогнозировать тяжелое течение и высокий риск осложнений, снизить вероятность их развития на фоне коронавирусной инфекции.
Результаты исследования выдаются с лабораторной интерпретацией, включающей оценку риска тяжелого течения ОРВИ, в том числе вызванной COVID-19.
В состав исследования входят:
- Клинический анализ крови (c лейкоцитарной формулой)
- Коагулограмма №1 (протромбин (по Квику), МНО)
- Аланинаминотрансфераза (АЛТ)
- Аспартатаминотрансфераза (АСТ)
- Гликированный гемоглобин (HbA1c)
- Глюкоза в плазме
- Креатинин в сыворотке (с определением СКФ)
- Лактатдегидрогеназа (ЛДГ) общая
- С-реактивный белок, количественно (высокочувствительный метод)
- Холестерин общий
Как правильно подготовиться к исследованию?
- Исключить из рациона алкоголь в течение 24 часов до исследования.
- Детям в возрасте до 1 года не принимать пищу в течение 30-40 минут до исследования.
- Детям в возрасте от 1 до 5 лет не принимать пищу в течение 2-3 часов до исследования.
- Не принимать пищу в течение 12 часов до исследования, можно пить чистую негазированную воду.
- Исключить физическое и эмоциональное перенапряжение в течение 30 минут до исследования.
- Не курить в течение 30 минут до исследования.
Цена исследования — 2300 р.